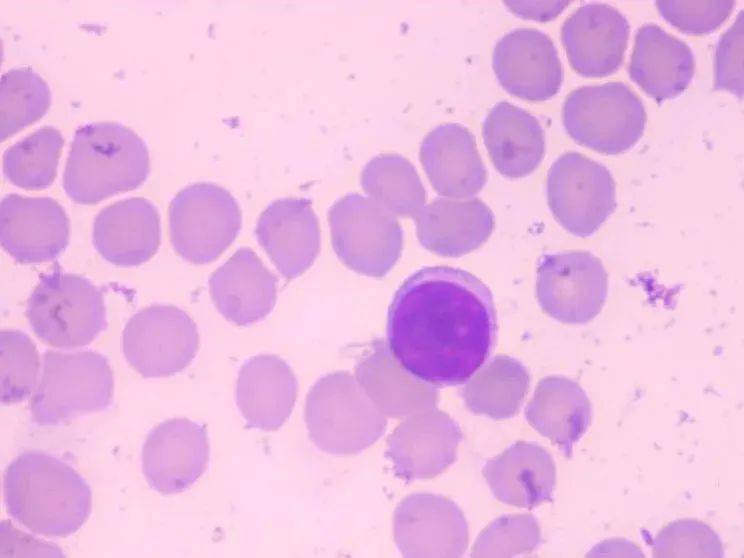
肠道|阑尾，是废物吗？

William Parker表示 , 达尔文在阑尾的问题上说错了 , 但这不怪他 , 当时细菌还没有被发现 。
阑尾的第二个作用是保护免疫系统 。
2017年 , 美国中西大学的Heather Smith研究了533种哺乳动物 , 发现许多互不相关的物种都有阑尾 。
阑尾作为哺乳动物的器官 , 已经存在了8000万年 , 在哺乳动物中至少已独立进化了32次 , 包括猩猩、考拉、鸭嘴兽、豪猪和海牛等 。
阑尾一定有重要的作用 , 不然不该被反复演化出来 。
人们发现 , 阑尾有高浓度的淋巴组织 , 能够产生淋巴细胞 。 淋巴细胞是体积最小的白细胞 , 是机体免疫应答功能的重要细胞成分 , 是淋巴系统几乎全部免疫功能的主要执行者 。 总之 , 是人体的士兵 。
文章图片
阑尾对维持人体健康也许具有一定好处(还待进一步石锤) , 但阑尾一旦发炎 , 确有可能危及生命 , 所以一旦腹部右下方出现剧痛 , 怀疑犯了阑尾炎 , 一定要及时就医 , 遵从医生的嘱托 , 该割就割 。

文章图片
世界上有成千上万割了阑尾的人 , 他们都活得好好的 。 但这段缺失无用的器官 , 却总能引起我们的思索 。
阑尾的功能的被发现 , 就像一个久已蒙尘的遗珠终于被世人发觉 。 在2021年的今天 , 我们最为熟悉的人体 , 仍有如此多的秘密等待探索 , 这感觉真的很神奇 。
一个看似没用的东西 , 既然存在 , 总有它的意义 。
资料来源:
https://williamparkerlab.org/the-appendix-as-a-safe-house/
https://blogs.scientificamerican.com/guest-blog/your-appendix-could-save-your-life/
https://www.sciencenewsforstudents.org/article/what-appendix-good
还想看?那是要加关注才行的
【肠道|阑尾,是废物吗?】点在看 , 捡起你的好奇心
- 血压|主动脉夹层可夺命?这五类人是高危人群,需高度重视
- 进行|尿毒症多半是“吃”出来的?3种食物尽量少碰,肾或许“感谢”你
- 苹果是天然润唇膏 你知道吗?
- 生活|提醒:肝病多数是“拖”出来的,出现6种表现,最好查一下肝功
- 羊肉|羊肉到底是“致癌杀手”还是“营养佳品”呢?世卫组织揭晓答案
- 肠镜|肠镜选无痛好还是普通好?二者有何区别?不妨听听医生的分析!
- 疫情|切莫上当!这些都是流调员绝不会问的问题
- 心血管疾病|这个病还是“夫妻病”,你知道吗?
- 晨跑|跑步有效延长寿命,但是晨跑和夜跑哪一个好?这才是最佳时间
- 小儿咳嗽可不都是肺热?小儿咳嗽也分好多种,你知道吗
